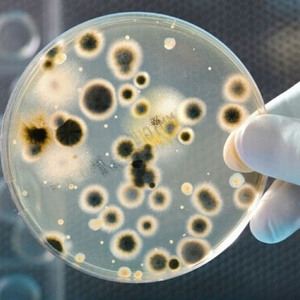

Лунинецкая районная ветеринарная станция ГУ
Райветстанция. Ветеринарные услуги. Лечение, профилактика, вакцинация.
Ветеринарные услуги, уход за животными
Райветстанция. Ветеринарные услуги. Лечение, профилактика, вакцинация.

Стерилизация и кастрация

Терапевтическое лечение

Проведение вакцинации

Ветеринарно-санитарная экспертиза

Оформление документов на животных в соответствии с законодательством РБ
Бактериологические анализы

Диагностика кожных заболеваний и другие исследования

Чипирование животных

Вакцинация от бешенства

Ветеринарная помощь

Ветеринарные анализы
Выезд ветврача на предприятие

Выезд ветврача на предприятие

Лечение сельскохозяйственных животных

Препараты для лечения животных

Ветеринария

Уход за сельскохозяйственными животными

Услуги ветеринарной лаборатории

Ветпрепараты

Лечение заболеваний животных

Ветеринарная терапия

Ветеринарная консультация

Ветеринарная хирургия

Вакцинация животных

Ветуслуги
Контактная информация
- +375 (1647) 4 75 xx (Приемная)
- +375 (1647) 3 13 xx (Бухгалтерия)
-
Пн
 08:00 - 17:00
08:00 - 17:00 13:00 - 14:00
13:00 - 14:00 -
Вт
 08:00 - 17:00
08:00 - 17:00 13:00 - 14:00
13:00 - 14:00 -
Ср
 08:00 - 17:00
08:00 - 17:00 13:00 - 14:00
13:00 - 14:00 -
Чт
 08:00 - 17:00
08:00 - 17:00 13:00 - 14:00
13:00 - 14:00 -
Пт
 08:00 - 17:00
08:00 - 17:00 13:00 - 14:00
13:00 - 14:00 -
СбВыходной
-
ВсВыходной
Контактное лицо

- Имя
- Секретарь

